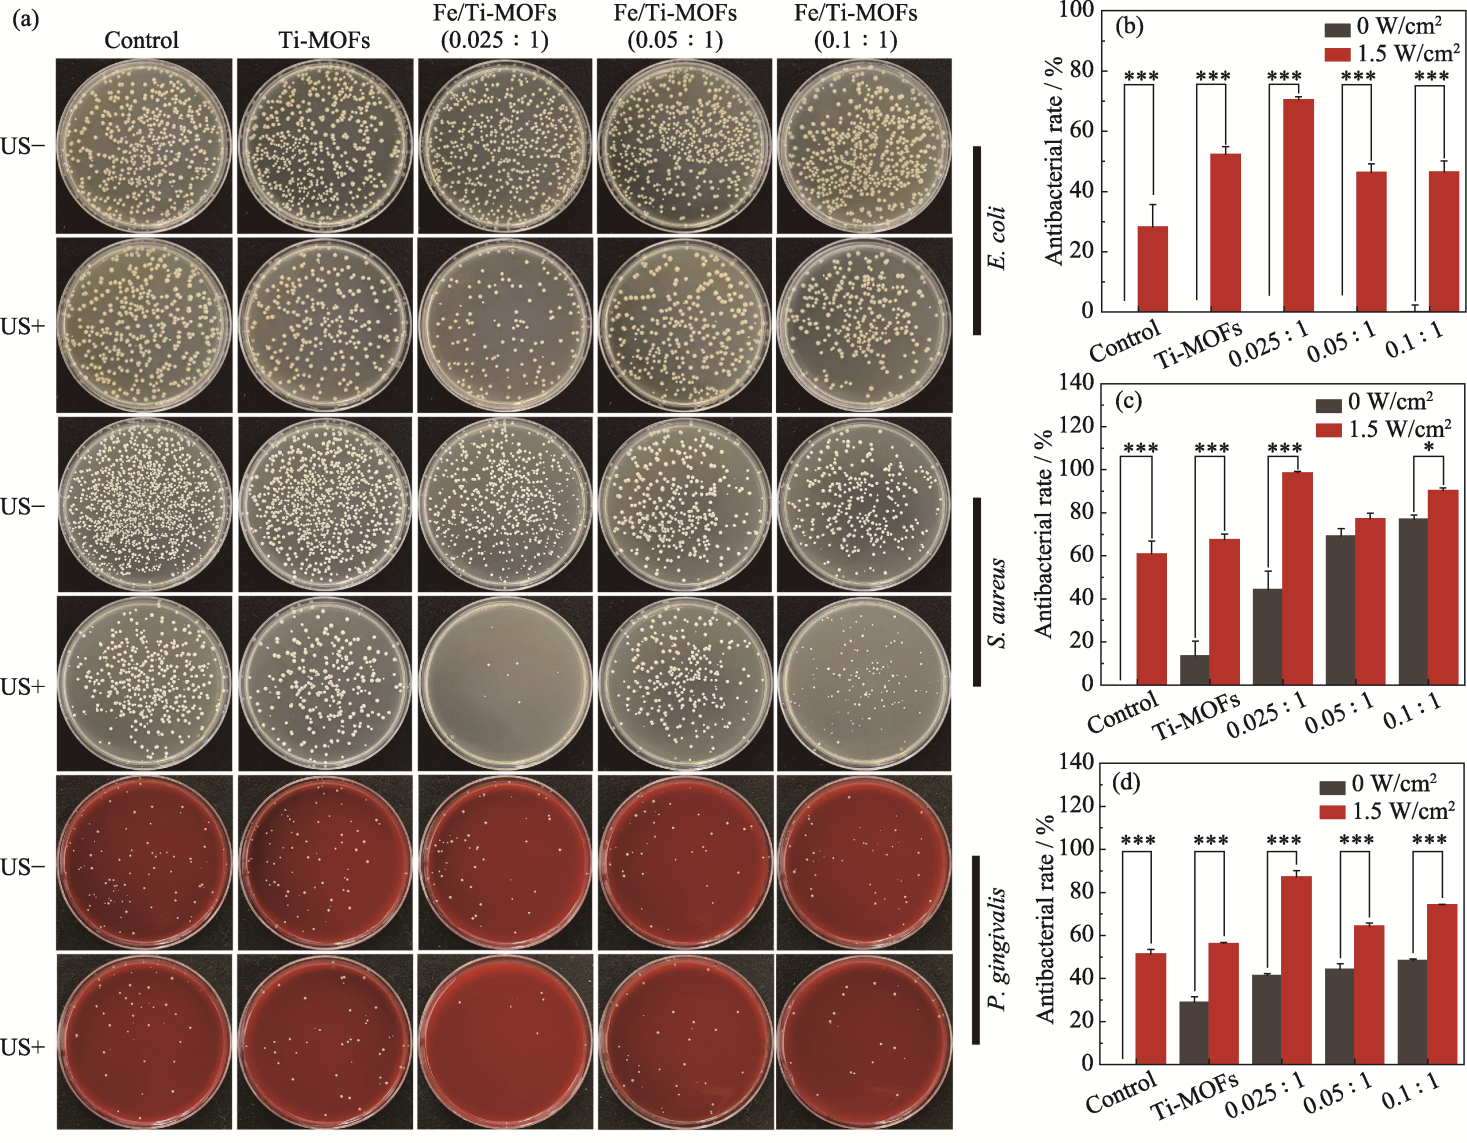

Journal of Inorganic Materials ›› 2026, Vol. 41 ›› Issue (4): 527-535.DOI: 10.15541/jim20250165
Previous Articles Next Articles
WANG Haoyu1,2( ), KE Xue1,2, GUAN Shiwei1,2, QIAN Shi1,2(
), KE Xue1,2, GUAN Shiwei1,2, QIAN Shi1,2( ), LIU Xuanyong1,2
), LIU Xuanyong1,2
Received:2025-04-19
Revised:2025-05-11
Published:2026-04-20
Online:2025-06-05
Contact:
QIAN Shi, professor. E-mail: qianshi@mail.sic.ac.cnAbout author:WANG Haoyu (2000-), male, Master candidate. E-mail: wanghaoyu222@mails.ucas.ac.cn
Supported by:CLC Number:
WANG Haoyu, KE Xue, GUAN Shiwei, QIAN Shi, LIU Xuanyong. Fe Doped Ti-MOFs for Enhanced Antibacterial Sonodynamic Therapy of Periodontitis[J]. Journal of Inorganic Materials, 2026, 41(4): 527-535.

Fig. 1 SEM images of Ti-MOFs (a1), Fe/Ti-MOFs (0.025 : 1) (a2), Fe/Ti-MOFs (0.05 : 1) (a3), and Fe/Ti-MOFs (0.1 : 1) (a4); XRD patterns (b), FT-IR spectra (c), and N2 adsorption desorption curves (d) of samples

Fig. 2 High resolution XPS spectra of Ti2p (a1-a4) and Fe2p (b1-b4) of Ti-MOFs, Fe/Ti-MOFs (0.025 : 1), Fe/Ti-MOFs (0.05 : 1), and Fe/Ti-MOFs (0.1 : 1)

Fig. 3 UV-Vis spectra (a), bandgap fitting (b), and photoelectric response (c) of Ti-MOFs, Fe/Ti-MOFs (0.025 : 1), Fe/Ti-MOFs (0.05 : 1), and Fe/Ti-MOFs (0.1 : 1)

Fig. 4 MB degradation efficiencies of samples (a), absorption curves of Fe/Ti-MOFs (0.025 : 1) before and after ultrasound at different powers (b), and ESR spectra of samples under ultrasound (c) Colorful figures are available on website
Fig. 5 Photos of re-cultivated bacterial colonies (a) and antibacterial rates against E. coli (b), S. aureus (c) and P. gingivalis (d) of Ti-MOFs, Fe/Ti-MOFs (0.025 : 1), Fe/Ti-MOFs (0.05 : 1), and Fe/Ti-MOFs (0.1 : 1) before and after ultrasonic treatment US+ and US- represent under ultrasonic and non-ultrasonic conditions, respectively. Colorful figures are available on website

Fig. 6 Live-dead staining images (a), cell proliferation (b), and hemolysis tests (c, d) of Ti-MOFs, Fe/Ti-MOFs (0.025 : 1), Fe/Ti-MOFs (0.05 : 1), and Fe/Ti-MOFs (0.1 : 1) Colorful figures are available on website
| Sample | H2BDC-NH2/g | Fe(acac)3/mg | TTIP/mL | DMF/mL | CH3OH/mL |
|---|---|---|---|---|---|
| Ti-MOFs | 2.72 | 0 | 1.15 | 45.0 | 5.00 |
| Fe/Ti-MOFs (0.025 : 1) | 2.72 | 33.1 | 1.15 | 45.0 | 5.00 |
| Fe/Ti-MOFs (0.05 : 1) | 2.72 | 66.1 | 1.15 | 45.0 | 5.00 |
| Fe/Ti-MOFs (0.1 : 1) | 2.72 | 132.2 | 1.15 | 45.0 | 5.00 |
Table S1 Raw material usage in preparation process of Fe/Ti-MOFs with different Fe : Ti ratios
| Sample | H2BDC-NH2/g | Fe(acac)3/mg | TTIP/mL | DMF/mL | CH3OH/mL |
|---|---|---|---|---|---|
| Ti-MOFs | 2.72 | 0 | 1.15 | 45.0 | 5.00 |
| Fe/Ti-MOFs (0.025 : 1) | 2.72 | 33.1 | 1.15 | 45.0 | 5.00 |
| Fe/Ti-MOFs (0.05 : 1) | 2.72 | 66.1 | 1.15 | 45.0 | 5.00 |
| Fe/Ti-MOFs (0.1 : 1) | 2.72 | 132.2 | 1.15 | 45.0 | 5.00 |
| Sample | Ti-MOFs | Fe/Ti-MOFs (0.025 : 1) | Fe/Ti-MOFs (0.05 : 1) | Fe/Ti-MOFs (0.1 : 1) | |
|---|---|---|---|---|---|
| (101) | Intensity | 1858 | 1405 | 1123 | 546 |
| FWHM/° | 0.196 | 0.192 | 0.238 | 0.317 | |
| (100) | Intensity | 483 | 386 | 382 | 205 |
| FWHM/° | 0.160 | 0.147 | 0.164 | 0.174 | |
| (001) | Intensity | 1885 | 1340 | 1093 | 631 |
| FWHM/° | 0.208 | 0.215 | 0.303 | 0.543 | |
| (211) | Intensity | 2171 | 1612 | 1427 | 865 |
| FWHM/° | 0.180 | 0.170 | 0.207 | 0.362 | |
Table S2 Diffraction peak parameters of different crystal planes of Ti-MOFs and different Fe/Ti-MOFs materials
| Sample | Ti-MOFs | Fe/Ti-MOFs (0.025 : 1) | Fe/Ti-MOFs (0.05 : 1) | Fe/Ti-MOFs (0.1 : 1) | |
|---|---|---|---|---|---|
| (101) | Intensity | 1858 | 1405 | 1123 | 546 |
| FWHM/° | 0.196 | 0.192 | 0.238 | 0.317 | |
| (100) | Intensity | 483 | 386 | 382 | 205 |
| FWHM/° | 0.160 | 0.147 | 0.164 | 0.174 | |
| (001) | Intensity | 1885 | 1340 | 1093 | 631 |
| FWHM/° | 0.208 | 0.215 | 0.303 | 0.543 | |
| (211) | Intensity | 2171 | 1612 | 1427 | 865 |
| FWHM/° | 0.180 | 0.170 | 0.207 | 0.362 | |
| Sample | SBET/(m2·g-1) | SDFT/(m2·g-1) | Vpore/(cm3·g-1) |
|---|---|---|---|
| Ti-MOFs | 1132.08 | 1722.72 | 0.69 |
| Fe/Ti-MOFs (0.025 : 1) | 1134.90 | 1702.66 | 0.66 |
| Fe/Ti-MOFs (0.05 : 1) | 1175.66 | 1736.29 | 0.74 |
| Fe/Ti-MOFs (0.1 : 1) | 1033.73 | 1533.40 | 0.77 |
Table S3 Specific surface area and pore volume data of Ti-MOFs and different Fe/Ti-MOFs
| Sample | SBET/(m2·g-1) | SDFT/(m2·g-1) | Vpore/(cm3·g-1) |
|---|---|---|---|
| Ti-MOFs | 1132.08 | 1722.72 | 0.69 |
| Fe/Ti-MOFs (0.025 : 1) | 1134.90 | 1702.66 | 0.66 |
| Fe/Ti-MOFs (0.05 : 1) | 1175.66 | 1736.29 | 0.74 |
| Fe/Ti-MOFs (0.1 : 1) | 1033.73 | 1533.40 | 0.77 |

Fig. S2 Full XPS spectra (a1-d1) and high-resolution C1s (a2-d2), N1s (a3-d3), and O1s (a4-d4) XPS spectra of Ti-MOFs, Fe/Ti-MOFs (0.025 : 1), Fe/Ti-MOFs (0.05 : 1), and Fe/Ti-MOFs (0.1 : 1)
| [1] | TAN X, LIU S, HU X, et al. Near-infrared-enhanced dual enzyme- mimicking Ag-TiO2-x@alginate microspheres with antibactericidal and oxygeneration abilities to treat periodontitis. ACS Applied Materials and Interfaces, 2023, 15(1): 391. |
| [2] |
MIYAUCHI S, KAWADA-MATSUO M, FURUSHO H, et al. Atrial translocation of Porphyromonas gingivalis exacerbates atrial fibrosis and atrial fibrillation. Circulation, 2025, 151(21): 1527.
DOI URL |
| [3] |
LIU H, NAN Z, ZHAO C, et al. Emerging synergistic strategies for enhanced antibacterial sonodynamic therapy: advances and prospects. Ultrasonics Sonochemistry, 2025, 116: 107288.
DOI URL |
| [4] |
ZHANG K, WANG T, HUANG X, et al. Ultrasound-mediated nanomaterials for the treatment of inflammatory diseases. Ultrasonics Sonochemistry, 2025, 114: 107270.
DOI URL |
| [5] |
LI K, XU W, CHEN Y, et al. Piezoelectric nanostructured surface for ultrasound-driven immunoregulation to rescue titanium implant infection. Advanced Functional Materials, 2023, 33(28): 2214522.
DOI URL |
| [6] |
CHEN H, LIU L, MA A, et al. Noninvasively immunogenic sonodynamic therapy with manganese protoporphyrin liposomes against triple-negative breast cancer. Biomaterials, 2021, 269: 120639.
DOI URL |
| [7] |
PAN X, WU N, TIAN S, et al. Inhalable MOF-derived nanoparticles for sonodynamic therapy of bacterial pneumonia. Advanced Functional Materials, 2022, 32(25): 2112145.
DOI URL |
| [8] |
QIN W, YANG Q, ZHU C, et al. A Distinctive insight into inorganic sonosensitizers: design principles and applicationdo- mains. Small, 2024, 20(25): 2311228.
DOI URL |
| [9] |
LI D, YANG Y, LI D, et al. Organic sonosensitizers for sonodynamic therapy: from small molecules and nanoparticles toward clinical development. Small, 2021, 17(42): 2101976.
DOI URL |
| [10] |
YANG F, DONG J, LI Z, et al. Metal-organic frameworks (MOF)-assisted sonodynamic therapy in anticancer applications. ACS Nano, 2023, 17(5): 4102.
DOI PMID |
| [11] |
DAN-HARDI M, SERRE C, FROT T, et al. A new photoactive crystalline highly porous titanium(IV) dicarboxylate. Journal of the American Chemical Society, 2009, 131(31): 10857.
DOI PMID |
| [12] |
VERMOORTELE F, MAES M, MOGHADAM P Z, et al. p-xylene-selective metal-organic frameworks: a case of topology-directed selectivity. Journal of the American Chemical Society, 2011, 133(46): 18526.
DOI URL |
| [13] |
NGUYEN H L. Perspectives on titanium-based metal-organic frameworks. Journal of Physics: Energy, 2021, 3(2): 021003.
DOI |
| [14] |
CHEN J, CHENG F, LUO D, et al. Recent advances in Ti-based MOFs in biomedical applications. Dalton Transactions, 2022, 51(39): 14817.
DOI URL |
| [15] |
LIANG S, XIAO X, BAI L, et al. Conferring Ti-based MOFs with defects for enhanced sonodynamic cancer therapy. Advanced Materials, 2021, 33(18): 2100333.
DOI URL |
| [16] |
WANG Q, TIAN Y, YAO M, et al. Bimetallic organic frameworks of high piezovoltage for sono-piezo dynamic therapy. Advanced Materials, 2023, 35(41): 2301784.
DOI URL |
| [17] |
LI Y, REN Z, HE Z, et al. Crystallinity-defect matching relationship of g-C3N4: experimental and theoretical perspectives. Green Energy and Environment, 2024, 9(4): 623.
DOI URL |
| [18] |
JIN Y, LIU F, LI Y, et al. Efficient adsorption of azo anionic dye Congo Red by micro-nano metal-organic framework MIL-68(Fe) and MIL-68(Fe) /chitosan composite sponge: preparation, characterization and adsorption performance. International Journal of Biological Macromolecules, 2023, 252: 126198.
DOI URL |
| [19] |
WANG Y, FENG W, LI J, et al. A novel route for the facile synthesis of NH2-MIL-53(Fe) and its highly efficient and selective adsorption of Congo Red. Inorganica Chimica Acta, 2023, 547: 121332.
DOI URL |
| [20] |
OLCZAK T, SIMPSON W, LIU X, et al. Iron and heme utilization in Porphyromonas gingivalis. FEMS Microbiology Reviews, 2005, 29(1): 119.
DOI URL |
| [21] | WÓJTOWICZ H, GUEVARA T, TALLANT C, et al. Unique structure and stability of HmuY, a novel heme-binding protein of Porphyromonas gingivalis. PLOS Pathogens, 2009, 5(5): e1000419. |
| [22] |
WANG X, ZHONG X, BAI L, et al. Ultrafine titanium monoxide (TiO1+x) nanorods for enhanced sonodynamic therapy. Journal of the American Chemical Society, 2020, 142(14): 6527.
DOI URL |
| [23] |
ZHANG D Y, LIU H, YOUNIS M R, et al. In-situ TiO2-x decoration of titanium carbide MXene for photo/sono-responsive antitumor theranostics. Journal of Nanobiotechnology, 2022, 20(1): 53.
DOI |
| [24] |
GUAN S, XU W, TAN J, et al. Metainterface heterostructure enhances sonodynamic therapy for disrupting secondary biofilms. ACS Nano, 2024, 18(23): 15114.
DOI PMID |
| [1] | WANG Meng, CAO Leilei, GOU Wangyan, CHENG Yayi, ZHAN Qi, YUAN Menglei. Tandem Catalysis of CuNi Bimetallic MOFs Boosting Nitrate Reduction for Ammonia Production [J]. Journal of Inorganic Materials, 2026, 41(5): 628-636. |
| [2] | LI Xuan, YE Kuicai, FENG Jiayin, QIU Jiajun, QIAN Wenhao, XING Min. Surface Modification of Titanium-based Dental Implants for Soft Tissue Sealing: A Review [J]. Journal of Inorganic Materials, 2026, 41(4): 432-444. |
| [3] | NIE Xiaoshuang, LI Dandan, WANG Fang, OUYANG Liping, LI Heng, QIU Jiajun. Ti3C2Tx Piezoelectric Composite Hydrogels for Bacterial-infected Skin Wound Healing [J]. Journal of Inorganic Materials, 2026, 41(2): 234-244. |
| [4] | JIANG Zongyu, HUANG Honghua, QING Jiang, WANG Hongning, YAO Chao, CHEN Ruoyu. Aluminum Ion Doped MIL-101(Cr): Preparation and VOCs Adsorption Performance [J]. Journal of Inorganic Materials, 2025, 40(7): 747-753. |
| [5] | ZHAO Lihua, WANG Yanshuai, YIN Xinwu, MAO Yeqiong, NIU Dechao. Bismuth Sulfide Nanoclusters-loaded Silica-based Hybrid Micelles: Preparation and Photothermal Antibacterial Property [J]. Journal of Inorganic Materials, 2025, 40(10): 1129-1136. |
| [6] | ZHANG Bo, FU Yimin, CHEN Zheng, SHI Ao, ZHU Min. Near-infrared Responsive Biphasic Antibacterial Mesoporous Bioactive Glass Composite Scaffolds: Preparation and Antibacterial Performance [J]. Journal of Inorganic Materials, 2025, 40(10): 1137-1144. |
| [7] | WANG Yueyue, HUANG Jiahui, KONG Hongxing, LI Huaizhu, YAO Xiaohong. Silver Loaded Radial Mesoporous Silica: Preparation and Application in Dental Resins [J]. Journal of Inorganic Materials, 2025, 40(1): 77-83. |
| [8] | LI Chengyu, DING Ziyou, HAN Yingchao. In vitro Antibacterial and Osteogenic Properties of Manganese Doped Nano Hydroxyapatite [J]. Journal of Inorganic Materials, 2024, 39(3): 313-320. |
| [9] | ZHANG Zhimin, GE Min, LIN Han, SHI Jianlin. Novel Magnetoelectric Catalytic Nanoparticles: RNS Release and Antibacterial Efficiency [J]. Journal of Inorganic Materials, 2024, 39(10): 1114-1124. |
| [10] | ZHANG Shumin, XI Xiaowen, SUN Lei, SUN Ping, WANG Deqiang, WEI Jie. Sonodynamic and Enzyme-like Activities of Niobium-based Coatings: Antimicrobial, Cell Proliferation and Cell Differentiation [J]. Journal of Inorganic Materials, 2024, 39(10): 1125-1134. |
| [11] | XIE Jiaye, LI Liwen, ZHU Qiang. Contrastive Study on in Vitro Antibacterial Property and Biocompatibility of Three Clinical Pulp Capping Agents [J]. Journal of Inorganic Materials, 2023, 38(12): 1449-1456. |
| [12] | DU Jiaheng, FAN Xinli, XIAO Dongqin, YIN Yiran, LI Zhong, HE Kui, DUAN Ke. Electrophoretic Coating of Magnesium Oxide on Microarc-oxidized Titanium and Its Biological Properties [J]. Journal of Inorganic Materials, 2023, 38(12): 1441-1448. |
| [13] | WU Xuetong, ZHANG Ruofei, YAN Xiyun, FAN Kelong. Nanozyme: a New Approach for Anti-microbial Infections [J]. Journal of Inorganic Materials, 2023, 38(1): 43-54. |
| [14] | SHENG Lili, CHANG Jiang. Photo/Magnetic Thermal Fe2SiO4/Fe3O4 Biphasic Bioceramic and Its Composite Electrospun Membrane: Preparation and Antibacterial [J]. Journal of Inorganic Materials, 2022, 37(9): 983-990. |
| [15] | HONG Jiahui, MA Ran, WU Yunchao, WEN Tao, AI Yuejie. CoNx/g-C3N4 Nanomaterials Preparation by MOFs Self-sacrificing Template Method for Efficient Photocatalytic Reduction of U(VI) [J]. Journal of Inorganic Materials, 2022, 37(7): 741-749. |
| Viewed | ||||||
|
Full text |
|
|||||
|
Abstract |
|
|||||